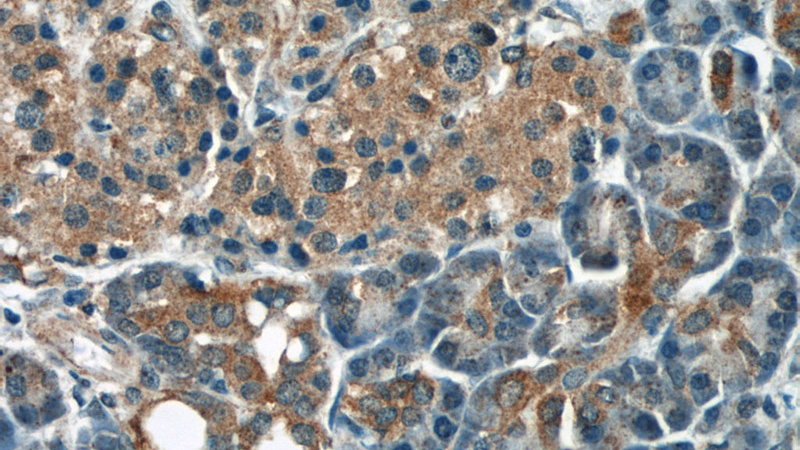
Immunohistochemical of paraffin-embedded human pancreas using Catalog No:110142(DYNLT1 antibody) at dilution of 1:50 (under 40x lens)

-
Product Name
DYNLT1 antibody
- Documents
-
Description
DYNLT1 Rabbit Polyclonal antibody. Positive IHC detected in human pancreas tissue. Positive WB detected in human brain tissue, human heart tissue, Sp2/0 cells. Positive IP detected in mouse skeletal muscle tissue. Observed molecular weight by Western-blot: 12 kDa
-
Tested applications
ELISA, WB, IHC, IP
-
Species reactivity
Human,Mouse,Rat; other species not tested.
-
Alternative names
CW 1 antibody; DYNLT1 antibody; Protein CW 1 antibody; TCTEL1 antibody; tctex 1 antibody; TCTEX1 antibody
-
Isotype
Rabbit IgG
-
Preparation
This antibody was obtained by immunization of DYNLT1 recombinant protein (Accession Number: NM_006519). Purification method: Antigen affinity purified.
-
Clonality
Polyclonal
-
Formulation
PBS with 0.1% sodium azide and 50% glycerol pH 7.3.
-
Storage instructions
Store at -20℃. DO NOT ALIQUOT
-
Applications
Recommended Dilution:
WB: 1:200-1:2000
IP: 1:200-1:1000
IHC: 1:20-1:200
-
Validations

human brain tissue were subjected to SDS PAGE followed by western blot with Catalog No:110142(DYNLT1 antibody) at dilution of 1:500
Immunohistochemical of paraffin-embedded human pancreas using Catalog No:110142(DYNLT1 antibody) at dilution of 1:50 (under 40x lens)

IP Result of anti-DYNLT1 (IP:Catalog No:110142, 4ug; Detection:Catalog No:110142 1:300) with mouse skeletal muscle tissue lysate 3600ug.
-
Background
DYNLT (or Tctex-1) was originally described as a light chain component of the dynein motor complex. Tctex-1 also has several dynein-independent functions, including roles in G protein signaling activation and neuronal growth. Tctex-1 is selectively enriched in proliferating neural progenitors of both embryonic and adult brains. Genetic knockdown of Tctex-1 in radial precursors promoted neurogenesis, indicating its implication in regulation of cortical neurogenesis. (Pubmed: 19448628)
-
References
- Gauthier-Fisher A, Lin DC, Greeve M, Kaplan DR, Rottapel R, Miller FD. Lfc and Tctex-1 regulate the genesis of neurons from cortical precursor cells. Nature neuroscience. 12(6):735-44. 2009.
- Kong S, Du X, Du X. Dlic1 deficiency impairs ciliogenesis of photoreceptors by destabilizing dynein. Cell research. 23(6):835-50. 2013.
- Nagler M, Palkowitsch L, Rading S, Moepps B, Karsak M. Cannabinoid receptor 2 expression modulates Gβ1γ2 protein interaction with the activator of G protein signalling 2/dynein light chain protein Tctex-1. Biochemical pharmacology. 99:60-72. 2016.
- Inaba H, Goto H, Kasahara K. Ndel1 suppresses ciliogenesis in proliferating cells by regulating the trichoplein-Aurora A pathway. The Journal of cell biology. 212(4):409-23. 2016.
Related Products / Services
Please note: All products are "FOR RESEARCH USE ONLY AND ARE NOT INTENDED FOR DIAGNOSTIC OR THERAPEUTIC USE"
